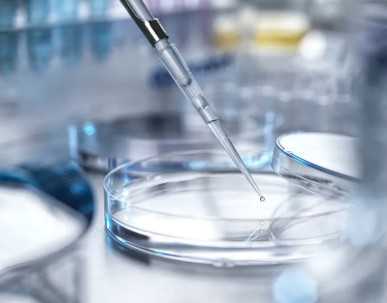
国内供卵高端机构有哪些,三峡大学附属仁和医院可以做试管婴儿吗？

作者:admin
日期:2025-05-23
三峡大学附属仁和医院暨三峡大学第二临床医学院,是三峡大学直属附属医院。始建于1967年,是一所集医疗、教学、科研、预防保健、康复于一体的三级甲等综合医院。立足于城东新区,辐射渝东鄂西,秉承“崇医尚德,仁和共生”的院训,服务宜昌医疗卫生事业,服务伍家岗区及周边县乡居民,保障地方百姓健康。
医院现有主院区、仁济院区、枝江铁路卫生所,设35个临床科室,10个医技科室。医院的诊疗设备先进,配置有飞利浦64排128层螺旋CT、GE1.5T及3.0T核磁共振、GE IGS 530血管造影机、高端彩超等各类大型高端医疗设备。
三峡大学附属仁和医院生殖医学中心建于2000年,是渝东鄂西地区最早开展辅助生殖技术及科研工作的大型医疗机构。中心占地面积近千平方米,分为门诊区和手术区。门诊区设有生殖内分泌与不育的专家门诊和普通门诊、男科门诊、B超诊断室、门诊手术室、宣教室及注射室等。生殖男科的设立为性功能障碍、逆行射精、梗阻性无精子症等提供了生育的平台。生殖中心实验室严格按照国家标准装修,各项指标均达到国家对生殖技术的要求。为确保“试管婴儿”操作环境的优质与稳定,现配有超净工作台、二氧化碳培养箱、三气培养箱、显微操作注射仪、激光破膜仪等先进设备。为“试管婴儿”技术提供了基本保障。
经过近20余年的努力,三峡大学附属仁和医院生殖医学科出色的完成了从无到有,从摸索到技术成熟,从先进到领先,试管婴儿周期累计达到8000余例,临床妊娠率已经稳定在50%,居省内前列。
此外,生殖中心每周定期组织业务学习,对于疑难、反复着床失败及特殊病例进行探讨。每年组织人员到全国顶级生殖中心学习,引进先进的技术借鉴丰富的经验,不断改进,不断创新,不断提高。每月科室还组织健康讲座,普及“试管婴儿”健康知识,面对面的解答患者在治疗中遇到的各种问题,竭诚为广大的患者服务。
该院生殖中心目前可开展的技术有:
1、不育症的诊断和治疗;
2、药物诱发排卵和控制性超排卵治疗;
3、夫精宫腔内人工授精;
4、常规体外受精与胚胎移植技术(第一代试管婴儿);
5、人卵胞浆内单精子显微注射技术(第二代试管婴儿);
6、冻融胚胎移植技术;
7、精子/胚胎的冷冻保存;
8、囊胚期胚胎培养与移植技术;
9、胚胎辅助孵化技术;
10、供精/供卵体外受精与胚胎移植技术;
11、睾丸/附睾穿刺技术;
12、多胎妊娠减胎技术;
13、卵巢囊肿穿刺术。
全国有哪些医院供卵医院,2026廊坊月子中心排名整理,广阳各家收费标准有所差别
国内供卵的流程,2026第二代试管婴儿全部费用明细目表一览
国内哪个医院捐卵,2026年三代试管***价格多少和你想象的不一样
国内代怀孕官网,2026第三代试管婴儿包生男孩费用需要多少?
国内哪里能做供卵,2026武汉试管婴儿医院排名榜名单正规机构价格多少很清楚
国内供卵医院在哪,2026马来西亚和泰国哪个做试管婴儿好
国内供卵排队,2026年鹤壁试管婴儿助孕医院最好排名一览
国内最可靠代怀,2026冷冻精子挂什么科、要啥手续全囊括,想留后路必看
全国供卵医院排名榜,漯河试管婴儿医院排名2026造娃价目表、*率参考
国内试管代怀产子机构代生,商丘助孕试管医院名单一览,2026试管收费价目表